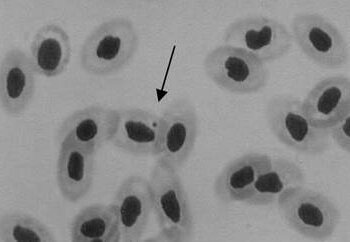
figura 1

Divulgação Científica
Adaptações respiratórias em peixes: os efeitos das vantagens evolutivas sobre o sucesso de espécies em ambientes extremos
Adaptações respiratórias em peixes: os efeitos das vantagens evolutivas sobre o sucesso de espécies em ambientes extremos Por Giorgi...
Read moreDetailsMonitoramento de ficotoxinas em cultivo de moluscos bivalves: uma questão de segurança alimentar
Monitoramento de ficotoxinas em cultivo de moluscos bivalves: uma questão desegurança alimentar Por Camila Prestes dos Santos Tavares Publicado...
Read moreDetailsIndustrialização de pescado de água doce – enlatamento
Industrialização de pescado de água doce - enlatamento Por Nathieli Cozer Publicado em 27/03/2015 A busca dos consumidores...
Read moreDetailsParasitose em linguados cultivados em laboratório
Parasitose em linguados cultivados em laboratório Por Gisela Geraldine Castilho-Westphall Publicado em 24/03/2015 FIGURA 1. Paralichthys orbignyanus (linguado manteiga ou...
Read moreDetailsO futuro depende da aquicultura em águas abertas
O futuro depende da aquicultura em águas abertas Por Diego Junqueira Stevanato Publicado em 20/03/2015 Para atendermos a crescente...
Read moreDetailsBalanço de nutrientes e qualidade da água em pisciculturas de tanque-rede com regime intensivo de produção
Balanço de nutrientes e qualidade da água em pisciculturas de tanque-rede com regime intensivo de produção Por Aline Horodesky Publicado...
Read moreDetailsE você, também gosta de camarão?
E você, também gosta de camarão? Por Rafael Fernández de Alaiza G. M. Publicado em 13/03/15 A apreciação...
Read moreDetailsA fotografia auxiliando o aprendizado
A fotografia auxiliando o aprendizado Por Thayzi O. Zeni Publicado em 11/03/2015 O uso de animais para pesquisas ou...
Read moreDetailsTestes de avaliação de genotoxicidade
Testes de avaliação de genotoxicidade Por: Thayzi O. Zeni Publicado em: 10/03/2015 Os cromossomos são amplamente utilizados em estudos...
Read moreDetailsMaricultura na China (segunda parte)
MARICULTURA NA CHINA (Segunda parte) Por Rafael Fernández de Alaiza G. M. Publicado em 19/01/15 Criação de tainha As...
Read moreDetails